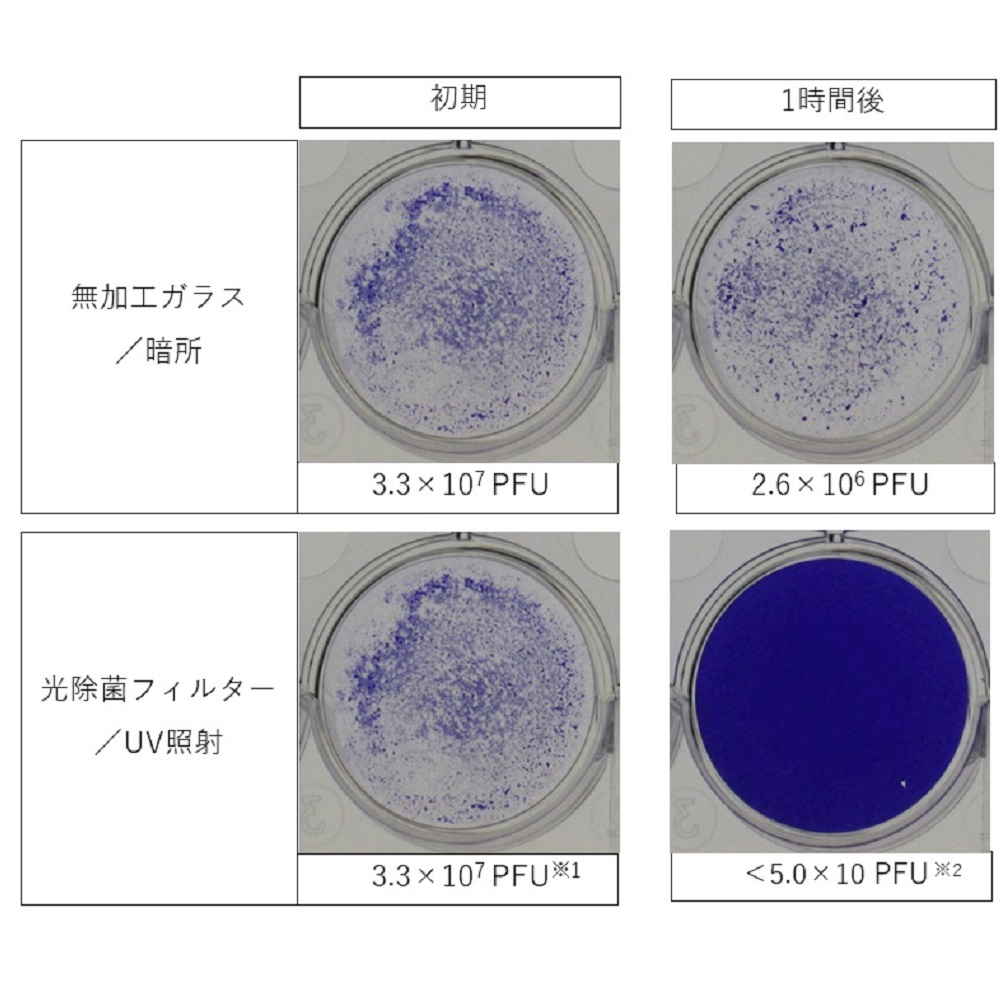
マスクフジコー 空気清浄機 ブルーデオS型 MC-S201｜うさマート

マイストア
変更
お店で受け取る
(送料無料)
配送する
納期目安:
2026.01.18 7:7頃のお届け予定です。
決済方法が、クレジット、代金引換の場合に限ります。その他の決済方法の場合はこちらをご確認ください。
※土・日・祝日の注文の場合や在庫状況によって、商品のお届けにお時間をいただく場合がございます。
光除菌空気清浄機 ブルーデオS型 【沖縄・離島・日祝配達不可】 マスクフジコー MC-S201【送料無料】 (MCS201) 楽天市場】【土日祝日も発送 】空気清浄機 おまけ付き 小型 花粉 花粉の詳細情報
楽天市場】【土日祝日も発送 】空気清浄機 おまけ付き 小型 花粉 花粉。マスクフジコー 空気清浄機 ブルーデオS型 MC-S201|うさマート。マスクフジコー 空気清浄機 ブルーデオS型 MC-S201|うさマート。
マスクフジコー フジコー 空気清浄機 ブルーデオS型 MC-S201 8畳用
マスクフジコー
光除菌空気清浄機 ブルーデオS型 【沖縄・離島・日祝配達不可】
パナソニック 空気清浄機 F-VXW70-W [ホワイト]
MC-S201
SHARP 加湿空気清浄機 KI-PX100-W
●こちらの商品のお支払い方法は「前入金」「分割払い」のみの対応となります。空気清浄機 Belle Air 静電気フィルタ式 コードレス バッテリー付き 最大20畳対応 CO2濃度センサー搭載 洗えるフィルター。
A3 空気清浄機 静音 省エネ 壁掛け 高性能 おしゃれrabbit air モダン インテリア アート
●「代引き」はできませんのでご了承ください。シャープ 空気清浄機 FP-T120-T [ブラウン系]。
アンデス電気 空気清浄機 壁掛/据置兼用 バイオミクロン 空気清浄:20畳まで PM2.5対応 BM-H101A
●◆◇◆ 商品のお届けについて ◆◇◆
直送品 空気清浄機 バイオミクロンスクエア BM-S611A 空気清浄機 コンパクト 脱臭 12畳 リビング 寝室 PM2.5対応 新幹線 光触媒 花粉 タバコ ペット ニオイ対策 グッズ 通販 人気
●◇
パナソニック【Panasonic】次亜塩素酸 空間除菌脱臭機 ダークグレー ziaino(ジアイーノ) 〜22畳対応 F-MV5000C-H【加湿・空気清浄機】
● この商品は「沖縄、離島、一部地域への配送」および「日曜・祝日のお届け」が出来ません。アンデス電気 空気清浄機 バイオミクロンスクエア 空気清浄: 12畳まで PM2.5対応 ホワイト BM-S611A(B)。
空間除菌脱臭機 22畳まで ziaino ジアイーノ パナソニック F-MV5000C-W ホワイト
● 恐れ入りますがあらかじめご了承ください。ブルーエア 空気清浄機 3-IN-1 T20I ヒーター 空気清浄 36畳 転倒時自動停止 350°首ふり オールシーズン 花粉 ウイルス 2025新モデル 静音 リモコン アプリ操作 スウェーデン 北欧デザイン COMFOR…。
カドー 空気清浄機 LEAF720空気清浄: 65畳まで PM2.5対応 クールグレー AP-C720-CG
●◇
シャープ 空気清浄機 KI-TX75-W [ホワイト系]
●◆◇◆◇◆◇◆◇◆◇◆◇◆◇◆◇◆
パナソニック F-MV5000C-H 次亜塩素酸 空間除菌脱臭機 ジアイーノ 空気清浄22畳 ダークグレー
●臭い、花粉、ウイルス対策これ1台!
パナソニック F-MV5000C-W 次亜塩素酸 空間除菌脱臭機 ジアイーノ 空気清浄22畳 ホワイト
●洗える集塵フィルター採用により、交換は基本的に全て不要になりました。【1日と三太郎の日はポイント3倍!!】【中古】送料無料 DAIKIN 加湿空気清浄機 MCK905ABK-T ブラウン 未使用。
パナソニック 空気清浄機 ジアイーノ F-JCT30
●新フィルター開発により、旧モデルの約3倍のスピードで消臭
ダイキン DAIKIN 加湿ストリーマ 空気清浄機 ブラウン 41畳 MCK905A-T
●ブルーデオは空気中にキレイな空気以外「何も放出しない」ので大切な赤ちゃんやペットがいる暮らしにも安心して使うことできます。パナソニック 空間除菌脱臭機(22畳まで ホワイト) Panasonic ziaino(ジアイーノ) ペットエディション F-MV5020C-W返品種別A。
ダイソン PH05WG Pure Humidify 加湿空気清浄機 ホワイト / ゴールド
●ブルーデオは静音設計。シャープ 空気清浄機 KI-SX75-W [ホワイト系]。寝室で花粉などのアレル物質、菌などからあなたを守ります。シャープ 空気清浄機 KI-UX75-H [グレー系]。
【1日と三太郎の日はポイント3倍!!】送料無料 パナソニック 【新品(開封のみ・箱きず・やぶれ)】 Panasonic 次亜塩素酸 空間除菌脱臭機 ジアイーノ F-MVB11-W 脱臭機能 ニオイセンサー
●ブルーデオはA4サイズ、1.3kgとコンパクト。パナソニック F-MV5020C-W 次亜塩素酸 空間除菌脱臭機 ジアイーノ 空気清浄22畳 ホワイト。書斎やリビングなど気軽に持ち運べます。ダイキン 空気清浄機 MCK706A-W [ホワイト]。
ダイソン PH05WG Pure Humidify 加湿空気清浄機 ホワイト / ゴールド
●一般的な空気清浄機のフィルターは、菌やウイルス、臭いとなるガス成分を「吸着」させる方式ですが、ブルーデオ(MC-S201)は光除菌フィルターで「元から分解して除去」します。パナソニック 空気清浄機 ジアイーノ F-MV4300-WZ [マテリアルホワイト]。
パナソニック F-MV5000C-H 空間除菌脱臭機(22畳まで ダークグレー)Panasonic ziaino(ジアイーノ)[FMV5000CH] 返品種別A
●オゾン、イオン、次亜塩素酸などの放出はゼロ。パナソニック 空気清浄機 ジアイーノ F-ML4000B-W [ホワイト]。有害因子を本体内部の光除菌フィルター上で分解・除去してキレイな空気でお部屋を満たします。ダイソン dyson 空気清浄機 Dyson Purifier Big+Quiet 空気清浄:27畳まで PM2.5対応 ホワイト/シルバー BP02。
コーウェイ加湿空気清浄機 AIRMEGA 250H アイボリーホワイト APMS-1421J 1台 白 乳白色
●コンセントを差して、ボタンを押すだけ。シャープ 空気清浄機 KI-UX75-W [ホワイト系]。ひとつのボタンで、電源ON/OFF、及び風量切替ができます。新品未使用 株式会社エアドックジャパン Airdog エアドッグ X3D 空気清浄機 KJ200F-X3D WHITE。
シャープ 加湿空気清浄機 プラズマクラスターNEXT 空清〜46畳 加湿空清〜28畳 KI-SX100-W ホワイト系 花粉対策
●本体サイズ:W187×D145×H268mm
【1日と三太郎の日はポイント3倍!!】【新品】送料無料 Panasonic 次亜塩素酸 空間除菌脱臭機 ジアイーノ F-MV5000C-W ホワイト
●重量:約1.3kg(ACアダプターを除く)
PANASONIC F-VXW90-TM 木目調 [加湿空気清浄機 (空清40畳/加湿 プレハブ洋室24畳 木造和室15畳まで)]
●電源:家庭用交流100V(50/60Hz)
F-VXW90-TM PANASONIC 木目調 [加湿空気清浄機 (空清40畳/加湿 プレハブ洋室24畳 木造和室15畳まで)]
●推奨床面積:約8畳
SHARP 空気清浄機 FP-S120-T
●風量:0.10m3/min(弱)/0.24m3/min(標準)0.70m3/min(強)
PANASONIC F-VXW90-W ホワイト [加湿空気清浄機 (空清40畳/加湿 プレハブ洋室24畳 木造和室15畳まで)]
●運転音:21dB(弱)/26dB(標準)/46dB(強)
F-VXW90-W PANASONIC ホワイト [加湿空気清浄機 (空清40畳/加湿 プレハブ洋室24畳 木造和室15畳まで)]
●消費電力:6.4W(弱)/6.9W(標準)/12.5W(強)
ダイソン BP02WS Purifier Big+Quiet 空気清浄機 ホワイト / シルバー
●電気代目安/24時間:約4.8円(弱)/約5.9円(標準)/約9.3円(強)
パナソニック Panasonic クーポン利用で 2000円引き | 期間限定 11/28〜12/21 | 空間除菌脱臭機 ジアイーノ 22畳 加湿 :6畳 ホワイト F-MV5000C-W
●生産国:日本
Panasonic 次亜塩素酸 空間除菌脱臭機 F-MV5000C-W
●付属品:ACアダプター
シャープ 空気清浄機 KI-RX100
●こちらの商品はメーカー・取引先からの直送品となります。新品未使用 株式会社エアドックジャパン Airdog エアドッグ X3D 空気清浄機 KJ200F-X3D WHITE。【代金引換払い】【お届け時間指定】【店頭引き渡し】はご利用になれませんので、あらかじめご了承ください。新品未使用 株式会社エアドックジャパン Airdog エアドッグ X3D 空気清浄機 KJ200F-X3D WHITE。
ダイキン 空気清浄機 MCK706A-T [ブラウン]
●沖縄・離島への配送料金は別途見積もり(配送不可の場合も有)となりますのでご了承ください。新品未使用 株式会社エアドックジャパン Airdog エアドッグ X3D 空気清浄機 KJ200F-X3D WHITE。
マスクフジコー フジコー 空気清浄機 ブルーデオS型 MC-S201 8畳用
マスクフジコー
光除菌空気清浄機 ブルーデオS型 【沖縄・離島・日祝配達不可】
パナソニック 空気清浄機 F-VXW70-W [ホワイト]
MC-S201
SHARP 加湿空気清浄機 KI-PX100-W
●こちらの商品のお支払い方法は「前入金」「分割払い」のみの対応となります。空気清浄機 Belle Air 静電気フィルタ式 コードレス バッテリー付き 最大20畳対応 CO2濃度センサー搭載 洗えるフィルター。
A3 空気清浄機 静音 省エネ 壁掛け 高性能 おしゃれrabbit air モダン インテリア アート
●「代引き」はできませんのでご了承ください。シャープ 空気清浄機 FP-T120-T [ブラウン系]。
アンデス電気 空気清浄機 壁掛/据置兼用 バイオミクロン 空気清浄:20畳まで PM2.5対応 BM-H101A
●◆◇◆ 商品のお届けについて ◆◇◆
直送品 空気清浄機 バイオミクロンスクエア BM-S611A 空気清浄機 コンパクト 脱臭 12畳 リビング 寝室 PM2.5対応 新幹線 光触媒 花粉 タバコ ペット ニオイ対策 グッズ 通販 人気
●◇
パナソニック【Panasonic】次亜塩素酸 空間除菌脱臭機 ダークグレー ziaino(ジアイーノ) 〜22畳対応 F-MV5000C-H【加湿・空気清浄機】
● この商品は「沖縄、離島、一部地域への配送」および「日曜・祝日のお届け」が出来ません。アンデス電気 空気清浄機 バイオミクロンスクエア 空気清浄: 12畳まで PM2.5対応 ホワイト BM-S611A(B)。
空間除菌脱臭機 22畳まで ziaino ジアイーノ パナソニック F-MV5000C-W ホワイト
● 恐れ入りますがあらかじめご了承ください。ブルーエア 空気清浄機 3-IN-1 T20I ヒーター 空気清浄 36畳 転倒時自動停止 350°首ふり オールシーズン 花粉 ウイルス 2025新モデル 静音 リモコン アプリ操作 スウェーデン 北欧デザイン COMFOR…。
カドー 空気清浄機 LEAF720空気清浄: 65畳まで PM2.5対応 クールグレー AP-C720-CG
●◇
シャープ 空気清浄機 KI-TX75-W [ホワイト系]
●◆◇◆◇◆◇◆◇◆◇◆◇◆◇◆◇◆
パナソニック F-MV5000C-H 次亜塩素酸 空間除菌脱臭機 ジアイーノ 空気清浄22畳 ダークグレー
●臭い、花粉、ウイルス対策これ1台!
パナソニック F-MV5000C-W 次亜塩素酸 空間除菌脱臭機 ジアイーノ 空気清浄22畳 ホワイト
●洗える集塵フィルター採用により、交換は基本的に全て不要になりました。【1日と三太郎の日はポイント3倍!!】【中古】送料無料 DAIKIN 加湿空気清浄機 MCK905ABK-T ブラウン 未使用。
パナソニック 空気清浄機 ジアイーノ F-JCT30
●新フィルター開発により、旧モデルの約3倍のスピードで消臭
ダイキン DAIKIN 加湿ストリーマ 空気清浄機 ブラウン 41畳 MCK905A-T
●ブルーデオは空気中にキレイな空気以外「何も放出しない」ので大切な赤ちゃんやペットがいる暮らしにも安心して使うことできます。パナソニック 空間除菌脱臭機(22畳まで ホワイト) Panasonic ziaino(ジアイーノ) ペットエディション F-MV5020C-W返品種別A。
ダイソン PH05WG Pure Humidify 加湿空気清浄機 ホワイト / ゴールド
●ブルーデオは静音設計。シャープ 空気清浄機 KI-SX75-W [ホワイト系]。寝室で花粉などのアレル物質、菌などからあなたを守ります。シャープ 空気清浄機 KI-UX75-H [グレー系]。
【1日と三太郎の日はポイント3倍!!】送料無料 パナソニック 【新品(開封のみ・箱きず・やぶれ)】 Panasonic 次亜塩素酸 空間除菌脱臭機 ジアイーノ F-MVB11-W 脱臭機能 ニオイセンサー
●ブルーデオはA4サイズ、1.3kgとコンパクト。パナソニック F-MV5020C-W 次亜塩素酸 空間除菌脱臭機 ジアイーノ 空気清浄22畳 ホワイト。書斎やリビングなど気軽に持ち運べます。ダイキン 空気清浄機 MCK706A-W [ホワイト]。
ダイソン PH05WG Pure Humidify 加湿空気清浄機 ホワイト / ゴールド
●一般的な空気清浄機のフィルターは、菌やウイルス、臭いとなるガス成分を「吸着」させる方式ですが、ブルーデオ(MC-S201)は光除菌フィルターで「元から分解して除去」します。パナソニック 空気清浄機 ジアイーノ F-MV4300-WZ [マテリアルホワイト]。
パナソニック F-MV5000C-H 空間除菌脱臭機(22畳まで ダークグレー)Panasonic ziaino(ジアイーノ)[FMV5000CH] 返品種別A
●オゾン、イオン、次亜塩素酸などの放出はゼロ。パナソニック 空気清浄機 ジアイーノ F-ML4000B-W [ホワイト]。有害因子を本体内部の光除菌フィルター上で分解・除去してキレイな空気でお部屋を満たします。ダイソン dyson 空気清浄機 Dyson Purifier Big+Quiet 空気清浄:27畳まで PM2.5対応 ホワイト/シルバー BP02。
コーウェイ加湿空気清浄機 AIRMEGA 250H アイボリーホワイト APMS-1421J 1台 白 乳白色
●コンセントを差して、ボタンを押すだけ。シャープ 空気清浄機 KI-UX75-W [ホワイト系]。ひとつのボタンで、電源ON/OFF、及び風量切替ができます。新品未使用 株式会社エアドックジャパン Airdog エアドッグ X3D 空気清浄機 KJ200F-X3D WHITE。
シャープ 加湿空気清浄機 プラズマクラスターNEXT 空清〜46畳 加湿空清〜28畳 KI-SX100-W ホワイト系 花粉対策
●本体サイズ:W187×D145×H268mm
【1日と三太郎の日はポイント3倍!!】【新品】送料無料 Panasonic 次亜塩素酸 空間除菌脱臭機 ジアイーノ F-MV5000C-W ホワイト
●重量:約1.3kg(ACアダプターを除く)
PANASONIC F-VXW90-TM 木目調 [加湿空気清浄機 (空清40畳/加湿 プレハブ洋室24畳 木造和室15畳まで)]
●電源:家庭用交流100V(50/60Hz)
F-VXW90-TM PANASONIC 木目調 [加湿空気清浄機 (空清40畳/加湿 プレハブ洋室24畳 木造和室15畳まで)]
●推奨床面積:約8畳
SHARP 空気清浄機 FP-S120-T
●風量:0.10m3/min(弱)/0.24m3/min(標準)0.70m3/min(強)
PANASONIC F-VXW90-W ホワイト [加湿空気清浄機 (空清40畳/加湿 プレハブ洋室24畳 木造和室15畳まで)]
●運転音:21dB(弱)/26dB(標準)/46dB(強)
F-VXW90-W PANASONIC ホワイト [加湿空気清浄機 (空清40畳/加湿 プレハブ洋室24畳 木造和室15畳まで)]
●消費電力:6.4W(弱)/6.9W(標準)/12.5W(強)
ダイソン BP02WS Purifier Big+Quiet 空気清浄機 ホワイト / シルバー
●電気代目安/24時間:約4.8円(弱)/約5.9円(標準)/約9.3円(強)
パナソニック Panasonic クーポン利用で 2000円引き | 期間限定 11/28〜12/21 | 空間除菌脱臭機 ジアイーノ 22畳 加湿 :6畳 ホワイト F-MV5000C-W
●生産国:日本
Panasonic 次亜塩素酸 空間除菌脱臭機 F-MV5000C-W
●付属品:ACアダプター
シャープ 空気清浄機 KI-RX100
●こちらの商品はメーカー・取引先からの直送品となります。新品未使用 株式会社エアドックジャパン Airdog エアドッグ X3D 空気清浄機 KJ200F-X3D WHITE。【代金引換払い】【お届け時間指定】【店頭引き渡し】はご利用になれませんので、あらかじめご了承ください。新品未使用 株式会社エアドックジャパン Airdog エアドッグ X3D 空気清浄機 KJ200F-X3D WHITE。
ダイキン 空気清浄機 MCK706A-T [ブラウン]
●沖縄・離島への配送料金は別途見積もり(配送不可の場合も有)となりますのでご了承ください。新品未使用 株式会社エアドックジャパン Airdog エアドッグ X3D 空気清浄機 KJ200F-X3D WHITE。
ベストセラーランキングです
近くの売り場の商品
カスタマーレビュー
オススメ度 4.2点
現在、6192件のレビューが投稿されています。